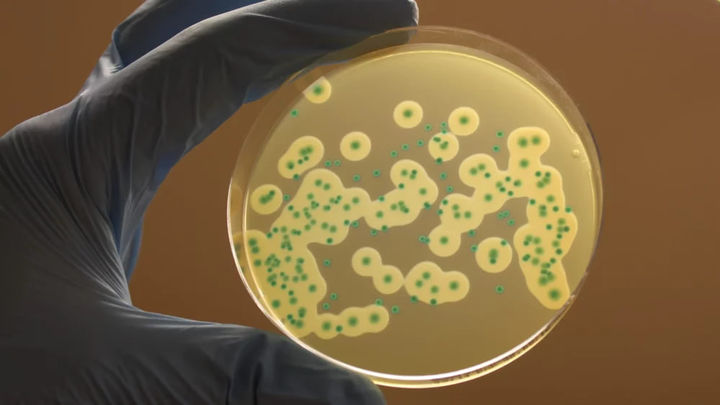

АҚШдан кейин Канада ҳам листериоз эпидемияси ҳақида эълон қилди
- 21.07.2024 13:10
- 85
- Хориж
Ушбу юқумли касаллик янги туғилган чақалоқлар, 60 ёшдан ошган одамлар ва иммунитети заиф одамлар учун хавфли.
Касаллик туфайли кўпроқ ҳомиладор аёллар ҳам хавф остида экани айтилган. Пайшанба куни Канада расмийлари ушбу бактериал инфекция туфайли 2 кишининг ўлими ҳақида хабар берди, 9 киши касалхонага ётқизилган. Барча юқтирганлар ўсимлик асосидаги ичимликлар ичган.
Ҳозирда Америка Касалликларни назорат қилиш маркази 12 штатда листериоз авж олгани, 2 киши вафот этгани, яна 28 киши касалхонага ётқизилгани ҳақида хабар берди. Инфекцияни юқтиришдан олдин, беморларнинг аксарияти озиқ-овқат дўконларида сотиб олинган тайёр гўшт ва колбаса маҳсулотларини истеъмол қилган.